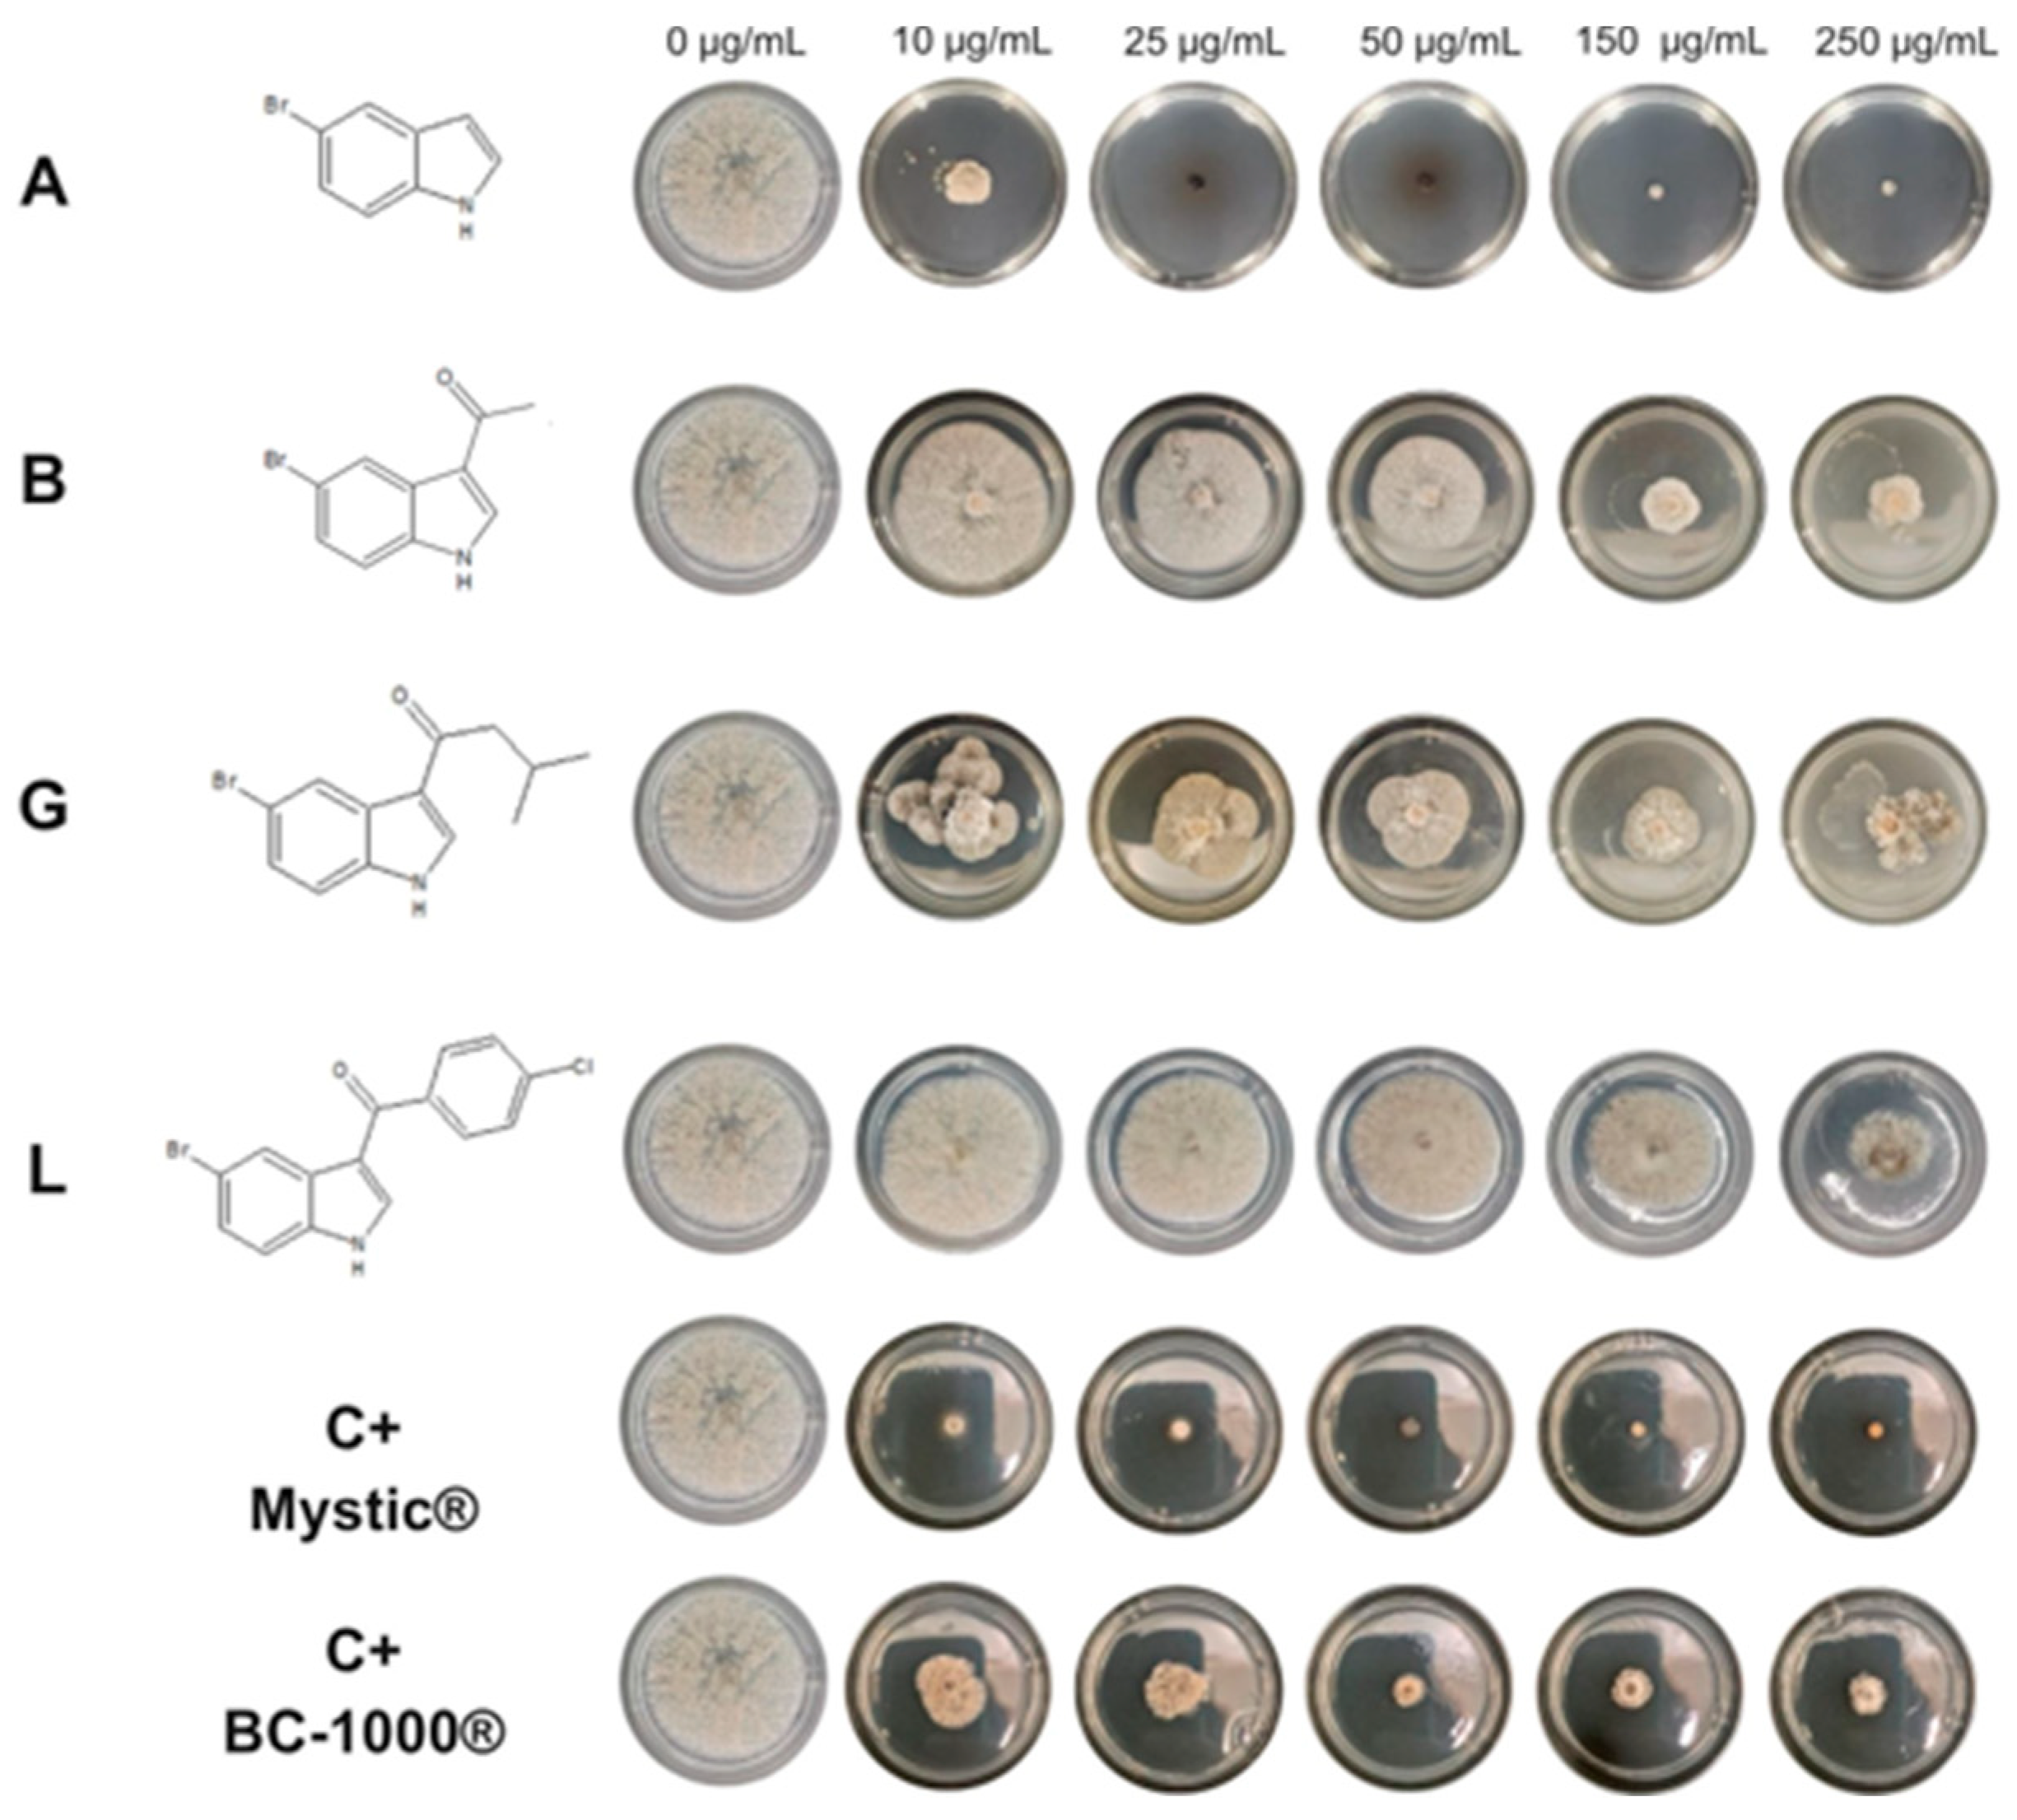
Ijms 26 09148 g001

An Efficient Microwave Synthesis of 3-Acyl-5-bromoindole Derivatives for Controlling Monilinia fructicola and Botrytis cinerea
Abstract
1. Introduction
2. Results and Discussion
2.1. Synthesized Compounds
2.2. Antifungal Activity
2.3. Molecular Docking
3. Materials and Methods
3.1. General
3.2. Synthesis of Compounds B–L
3.3. In Vitro Antifungal Activity of Indol and Synthetized Compounds (A–L) Against Phytopathogenic Fungi
3.3.1. Fungal Growing Conditions
3.3.2. Effect of the Compounds on the Micelial Growth of M. fructicola and B. cinerea In Vitro
3.3.3. Effect of the Compounds on Conidial Germination
3.4. Molecular Docking
4. Conclusions
Supplementary Materials
Author Contributions
Funding
Institutional Review Board Statement
Data Availability Statement
Acknowledgments
Conflicts of Interest
References
- Kaushik, N.K.; Kaushik, N.; Attri, P.; Kumar, N.; Kim, C.; Verma, A.; Choi, E. Biomedical Importance of Indoles. Molecules 2013, 18, 6620–6662. [Google Scholar] [CrossRef]
- Fernández, S.; Arnáiz, V.; Rufo, D.; Arroyo, Y. Current Status of Indole-Derived Marine Natural Products: Synthetic Approaches and Therapeutic Applications. Mar. Drugs 2024, 22, 126. [Google Scholar] [CrossRef] [PubMed]
- Dadashpour, S.; Emami, S. Indole in the Target-Based Design of Anticancer Agents: A Versatile Scaffold with Diverse Mechanisms. Eur. J. Med. Chem. 2018, 150, 9–29. [Google Scholar] [CrossRef]
- Bajad, N.G.; Singh, S.K.; Singh, S.K.; Singh, T.D.; Singh, M. Indole: A Promising Scaffold for the Discovery and Development of Potential Anti-Tubercular Agents. Curr. Res. Pharmacol. Drug Discov. 2022, 3, 100119. [Google Scholar] [CrossRef]
- Zhang, M.-Z.; Chen, Q.; Yang, G.-F. A Review on Recent Developments of Indole-Containing Antiviral Agents. Eur. J. Med. Chem. 2015, 89, 421–441. [Google Scholar] [CrossRef] [PubMed]
- Singh, T.P.; Singh, O.M. Recent Progress in Biological Activities of Indole and Indole Alkaloids. Mini-Rev. Med. Chem. 2017, 18, 9–25. [Google Scholar] [CrossRef] [PubMed]
- Miller, S.A.; Ferreira, J.P.; LeJeune, J.T. Antimicrobial Use and Resistance in Plant Agriculture: A One Health Perspective. Agriculture 2022, 12, 289. [Google Scholar] [CrossRef]
- Mustafa, M.H.; Bassi, D.; Corre, M.-N.; Lino, L.O.; Signoret, V.; Quilot-Turion, B.; Cirilli, M. Phenotyping Brown Rot Susceptibility in Stone Fruit: A Literature Review with Emphasis on Peach. Horticulturae 2021, 7, 115. [Google Scholar] [CrossRef]
- Rupp, S.; Weber, R.W.S.; Rieger, D.; Detzel, P.; Hahn, M. Spread of Botrytis Cinerea Strains with Multiple Fungicide Resistance in German Horticulture. Front. Microbiol. 2017, 7, 2075. [Google Scholar] [CrossRef]
- Bai, Y.; Hou, Y.; Wang, Q.; Lu, C.; Ma, X.; Wang, Z.; Xu, H. Analysis of the Binding Modes and Resistance Mechanism of Four Methyl Benzimidazole Carbamates Inhibitors Fungicides with Monilinia Fructicola Β2-Tubulin Protein. J. Mol. Struct. 2023, 1291, 136057. [Google Scholar] [CrossRef]
- Wu, Z.; Bi, Y.; Zhang, J.; Gao, T.; Li, X.; Hao, J.; Li, G.; Liu, P.; Liu, X. Multidrug Resistance of Botrytis Cinerea Associated with Its Adaptation to Plant Secondary Metabolites. mBio 2024, 15, e02237-23. [Google Scholar] [CrossRef]
- Zhang, Y.; Li, J.; Li, K.; Gao, Z.; Tang, L.; Fan, Z. Investigation of the Antifungal Activity and Preliminary Mode of Action of Novel 2-(1 H-Indol-2-Yl)-1,3,4-Oxadiazole Derivatives against Botrytis Cinerea. J. Agric. Food Chem. 2025, 73, 5792–5802. [Google Scholar] [CrossRef]
- Sofan, M.A.; El-Ablack, F.Z.; Elsayed, A.I. Antimicrobial Activity of N-Substituted Derivatives of 5-Chloro-2,3- Diphenyl Indole. ChemistrySelect 2023, 8, e202302922. [Google Scholar] [CrossRef]
- Dekker, W.H.; Selling, H.A.; Overeem, J.C. Structure-Activity Relations of Some Antifungal Indoles. J. Agric. Food Chem. 1975, 23, 785–791. [Google Scholar] [CrossRef] [PubMed]
- Tiwari, S.; Talreja, S. Green Chemistry and Microwave Irradiation Technique: A Review. J. Pharm. Res. Int. 2022, 74–79. [Google Scholar] [CrossRef]
- Lai, Q.Y.; Liao, R.S.; Wu, S.Y.; Zhang, J.X.; Duan, X.H. A Novel Microwave-Irradiated Solvent-Free 3-Acylation of Indoles on Alumina. New J. Chem. 2013, 37, 4069. [Google Scholar] [CrossRef]
- Bai, G.; Li, T.; Yang, Y.; Zhang, H.; Lan, X.; Li, F.; Han, J.; Ma, Z.; Chen, Q.; Chen, G. Microwave-Assisted Friedel–Crafts Acylation of Indole with Acetic Anhydride over Tungstophosphoric Acid Modified Hβ Zeolite. Catal. Commun. 2012, 29, 114–117. [Google Scholar] [CrossRef]
- Tran, P.; Tran, H.; Hansen, P.; Do, M.; Le, T. A Simple, Effective, Green Method for the Regioselective 3-Acylation of Unprotected Indoles. Molecules 2015, 20, 19605–19619. [Google Scholar] [CrossRef]
- Na, Y.; Borgne, M.L.; Pagniez, F.; Le Baut, G.; Le Pape, P. Synthesis and Antifungal Activity of New 1-Halogenobenzyl-3-Imidazolylmethylindole Derivatives. Eur. J. Med. Chem. 2003, 38, 75–87. [Google Scholar] [CrossRef]
- Borgne, M.L.; Marchand, P.; Nourrisson, M.-R.; Loquet, D.; Palzer, M.; Le Baut, G.; Hartmann, R.W. Synthesis and Biological Evaluation of 3-(Azolylmethyl)-1H-Indoles and 3-(α-Azolylbenzyl)-1H-Indoles as Selective Aromatase Inhibitors. J. Enzyme Inhib. Med. Chem. 2007, 22, 667–676. [Google Scholar] [CrossRef]
- Wang, C.; Wang, S.; Li, H.; Yan, J.; Chi, H.; Chen, X.; Zhang, Z. Copper-Catalyzed Decarboxylative C3-Acylation of Free (N–H) Indoles with α-Oxocarboxylic Acids. Org. Biomol. Chem. 2014, 12, 1721. [Google Scholar] [CrossRef] [PubMed]
- Amich, J.; Bromley, M.; Goldman, G.H.; Valero, C. Toward the Consensus of Definitions for the Phenomena of Antifungal Tolerance and Persistence in Filamentous Fungi. mBio 2025, 16, e03475-24. [Google Scholar] [CrossRef]
- Bi, K.; Liang, Y.; Mengiste, T.; Sharon, A. Killing Softly: A Roadmap of Botrytis Cinerea Pathogenicity. Trends Plant Sci. 2023, 28, 211–222. [Google Scholar] [CrossRef] [PubMed]
- Raorane, C.J.; Raj, V.; Lee, J.-H.; Lee, J. Antifungal Activities of Fluoroindoles against the Postharvest Pathogen Botrytis Cinerea: In Vitro and in Silico Approaches. Int. J. Food Microbiol. 2022, 362, 109492. [Google Scholar] [CrossRef] [PubMed]
- Dhiman, A.; Sharma, R.; Singh, R.K. Target-Based Anticancer Indole Derivatives and Insight into Structure—Activity Relationship: A Mechanistic Review Update (2018–2021). Acta Pharm. Sin. B. 2022, 12, 3006–3027. [Google Scholar] [CrossRef]
- Zhao, Y.; Zhang, A.; Wang, X.; Tao, K.; Jin, H.; Hou, T. Novel Pyrazole Carboxamide Containing a Diarylamine Scaffold Potentially Targeting Fungal Succinate Dehydrogenase: Antifungal Activity and Mechanism of Action. J. Agric. Food Chem. 2022, 70, 13464–13472. [Google Scholar] [CrossRef]
- Luo, X.; Chen, Y.; Wang, Y.; Xing, Z.; Peng, J.; Chen, J. Design, Synthesis and Antifungal Activity of Novel Amide Derivatives Containing a Pyrrolidine Moiety as Potential Succinate Dehydrogenase Inhibitors. Mol. Divers. 2024, 28, 805–816. [Google Scholar] [CrossRef]
- Zhang, Y.-H.; Yang, S.-S.; Zhang, Q.; Zhang, T.-T.; Zhang, T.-Y.; Zhou, B.-H.; Zhou, L. Discovery of N -Phenylpropiolamide as a Novel Succinate Dehydrogenase Inhibitor Scaffold with Broad-Spectrum Antifungal Activity on Phytopathogenic Fungi. J. Agric. Food Chem. 2023, 71, 3681–3693. [Google Scholar] [CrossRef]
- Ma, Z.; Qiu, S.; Zhang, D.; Guo, X.; Lu, Y.; Fan, Y.; Chen, X. Design, Synthesis, and Antifungal Activity of Novel Dithiin Tetracarboximide Derivatives as Potential Succinate Dehydrogenase Inhibitors. Pest. Manag. Sci. 2023, 79, 1922–1930. [Google Scholar] [CrossRef]
- Cramer, J.; Sager, C.P.; Ernst, B. Hydroxyl Groups in Synthetic and Natural-Product-Derived Therapeutics: A Perspective on a Common Functional Group. J. Med. Chem. 2019, 62, 8915–8930. [Google Scholar] [CrossRef]
- Yadav, S.; Aslam, M.; Prajapat, A.; Massey, I.; Nand, B.; Kumar, D.; Kumari, K.; Pandey, G.; Verma, C.; Singh, P.; et al. Investigate the Binding of Pesticides with the TLR4 Receptor Protein Found in Mammals and Zebrafish Using Molecular Docking and Molecular Dynamics Simulations. Sci. Rep. 2024, 14, 24504. [Google Scholar] [CrossRef] [PubMed]
- Huang, Z.; Huang, Q.; Wei, H.; Chen, J.; Wang, J.; Song, G. Fluopyram analogues containing an indole moiety: Synthesis, biological activity and molecular docking study. Mol. Divers. 2025, 1–15. [Google Scholar] [CrossRef] [PubMed]
- Yang, J.; Zhao, Y.; Wan, J.; Jiang, M.; Jin, H.; Tao, K.; Hou, T. Synthesis and Biological Evaluation of Novel Benodanil-Heterocyclic Carboxamide Hybrids as a Potential Succinate Dehydrogenase Inhibitors. Molecules 2020, 25, 4291. [Google Scholar] [CrossRef] [PubMed]
- Ferreira, C.; Silva, V.; Muñoz, E.; Valle, G.; Martínez-Lobos, M.; Valdés, F.; Díaz, K.; Montenegro, I.; Godoy, P.; Caro, N.; et al. The Effect of 3′,4′-Methylenedioxychalcone Derivatives on Mycelial Growth and Conidial Germination of Monilinia fructicola: An In Silico and In Vitro Study. Agriculture 2025, 15, 983. [Google Scholar] [CrossRef]
- Madrid, A.; Silva, V.; Reyes, C.; Werner, E.; Besoain, X.; Montenegro, I.; Muñoz, E.; Díaz, K. Control of Peach Brown Rot Disease Produced by Monilinia Fructicola and Monilinia Laxa Using Benzylidene-Cycloalkanones. J. Fungi 2024, 10, 609. [Google Scholar] [CrossRef]

| Compound | Monilinia fructicola (µg/mL) ± SD | Conidia a (%) | Botrytis cinerea (µg/mL) ± SD | Conidia b (%) |
|---|---|---|---|---|
| Indole | 62.85 ± 0.08 | 5 | 168.03 ± 0.03 | 36 |
| A | 7.91 ± 0.11 | 5 | 12.17 ± 0.07 | 18 |
| B | 53.6 ± 0.54 | 23 | >250 | I |
| C | >250 | I | >250 | I |
| D | >250 | I | >250 | I |
| E | >250 | I | >250 | I |
| F | >250 | I | >250 | I |
| G | 36.92 ± 0.44 | 14 | >250 | I |
| H | >250 | I | >250 | I |
| I | >250 | I | >250 | I |
| J | >250 | I | 208.7 ± 0.83 | 63 |
| K | >250 | I | >250 | I |
| L | 240.45 ± 0.86 | 81 | >250 | I |
| BC-1000® | <10 | 84 | 95.13 ± 0.67 | 100 |
| Captan® | - | - | 82.89 ± 0.69 | 100 |
| Mystic® | <10 | 85 | - | - |
| Compound | Binding Energy (Kcal/mol) | Interactions |
|---|---|---|
| A | −6.81 | Asp232; Ser229; Lys49; Val 24 |
| B | −6.56 | Asp 232; Leu50; Lys49; Gly25 |
| C | −5.16 | Asp232; Lys49; Leu50 |
| D | −5.07 | Asp232; Thr48; Ala178; Leu50; Gly25; Lys49 |
| E | −5.71 | Gly27; Hse56; Leu50; Gly27; Leu417 |
| F | −5.08 | Asp232; Thr48; Val24; Gly25; Leu50; Lys49 |
| G | −6.79 | Asp232; Thr48; Ala178; Phe177; Lys49; Val24 |
| H | −5.68 | Thr48; Thr213; Ala178; Lys49 |
| I | −5.52 | Ser229; Tyr365; Leu417; Asp232 |
| J | −5.98 | Ser413; Gly397; Glu397; Leu417 |
| K | −5.43 | Ser413; Gly27; Ala212; Leu 413 |
| L | −5.98 | Ala212; Gly27; Leu417; Leu414 |
Disclaimer/Publisher’s Note: The statements, opinions and data contained in all publications are solely those of the individual author(s) and contributor(s) and not of MDPI and/or the editor(s). MDPI and/or the editor(s) disclaim responsibility for any injury to people or property resulting from any ideas, methods, instructions or products referred to in the content. |
© 2025 by the authors. Licensee MDPI, Basel, Switzerland. This article is an open access article distributed under the terms and conditions of the Creative Commons Attribution (CC BY) license (https://creativecommons.org/licenses/by/4.0/).
Share and Cite
Silva, V.; Muñoz, E.; Díaz, K.; Molina, P.; Besoain, X.; Montenegro, I.; Rigano, D.; Caro, N.; Madrid, A. An Efficient Microwave Synthesis of 3-Acyl-5-bromoindole Derivatives for Controlling Monilinia fructicola and Botrytis cinerea. Int. J. Mol. Sci. 2025, 26, 9148. https://doi.org/10.3390/ijms26189148
Silva V, Muñoz E, Díaz K, Molina P, Besoain X, Montenegro I, Rigano D, Caro N, Madrid A. An Efficient Microwave Synthesis of 3-Acyl-5-bromoindole Derivatives for Controlling Monilinia fructicola and Botrytis cinerea. International Journal of Molecular Sciences. 2025; 26(18):9148. https://doi.org/10.3390/ijms26189148
Chicago/Turabian StyleSilva, Valentina, Evelyn Muñoz, Katy Díaz, Paula Molina, Ximena Besoain, Iván Montenegro, Daniela Rigano, Nelson Caro, and Alejandro Madrid. 2025. "An Efficient Microwave Synthesis of 3-Acyl-5-bromoindole Derivatives for Controlling Monilinia fructicola and Botrytis cinerea" International Journal of Molecular Sciences 26, no. 18: 9148. https://doi.org/10.3390/ijms26189148
APA StyleSilva, V., Muñoz, E., Díaz, K., Molina, P., Besoain, X., Montenegro, I., Rigano, D., Caro, N., & Madrid, A. (2025). An Efficient Microwave Synthesis of 3-Acyl-5-bromoindole Derivatives for Controlling Monilinia fructicola and Botrytis cinerea. International Journal of Molecular Sciences, 26(18), 9148. https://doi.org/10.3390/ijms26189148

